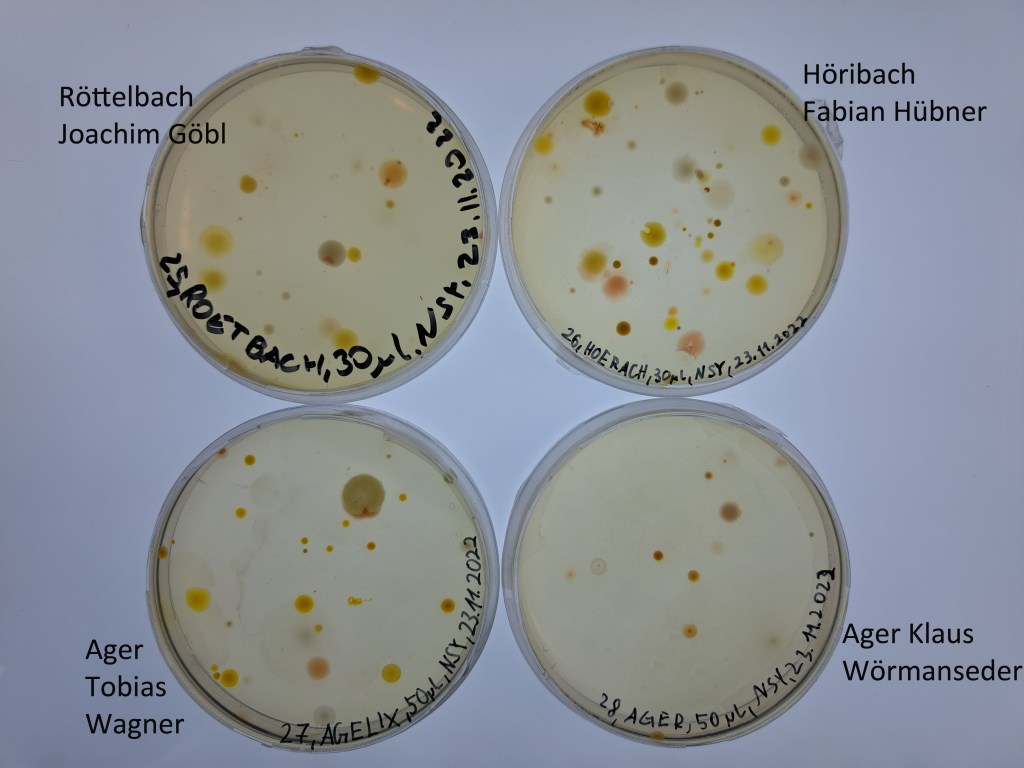
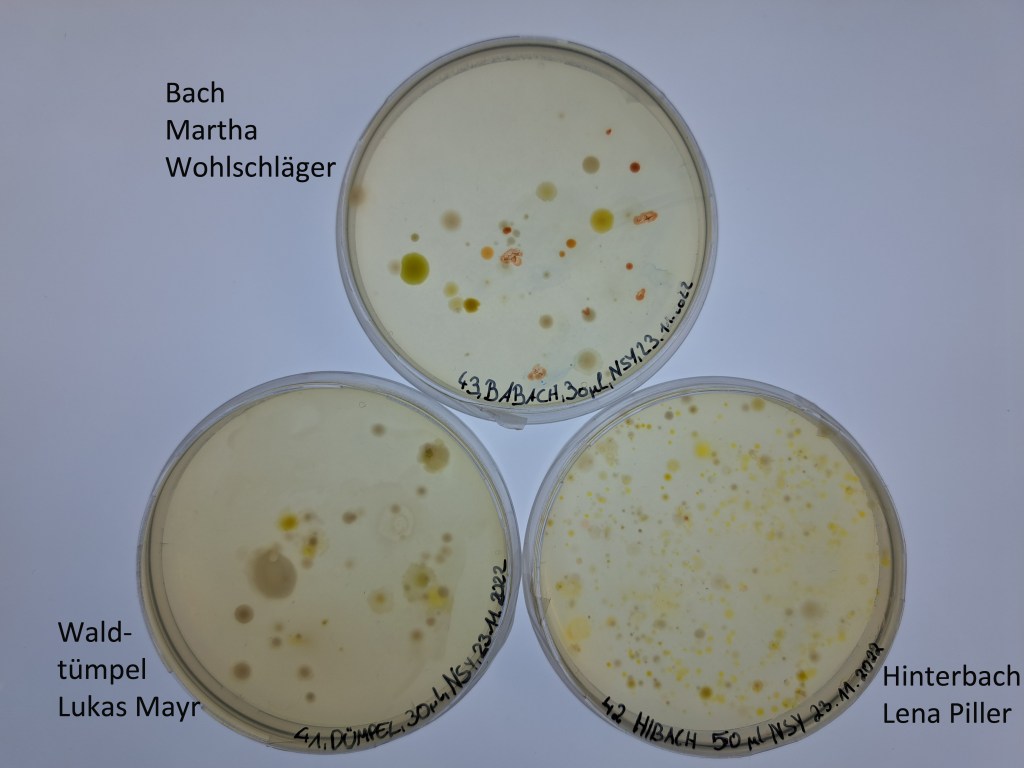
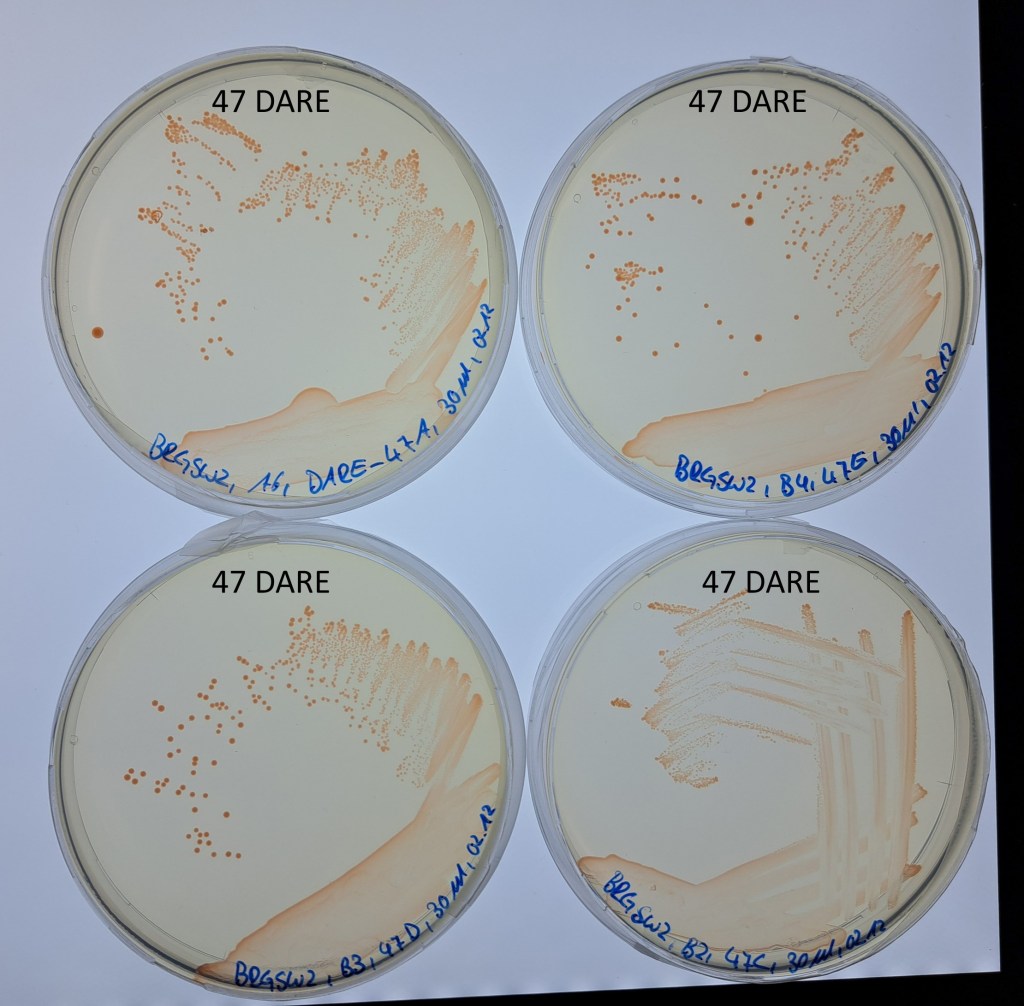
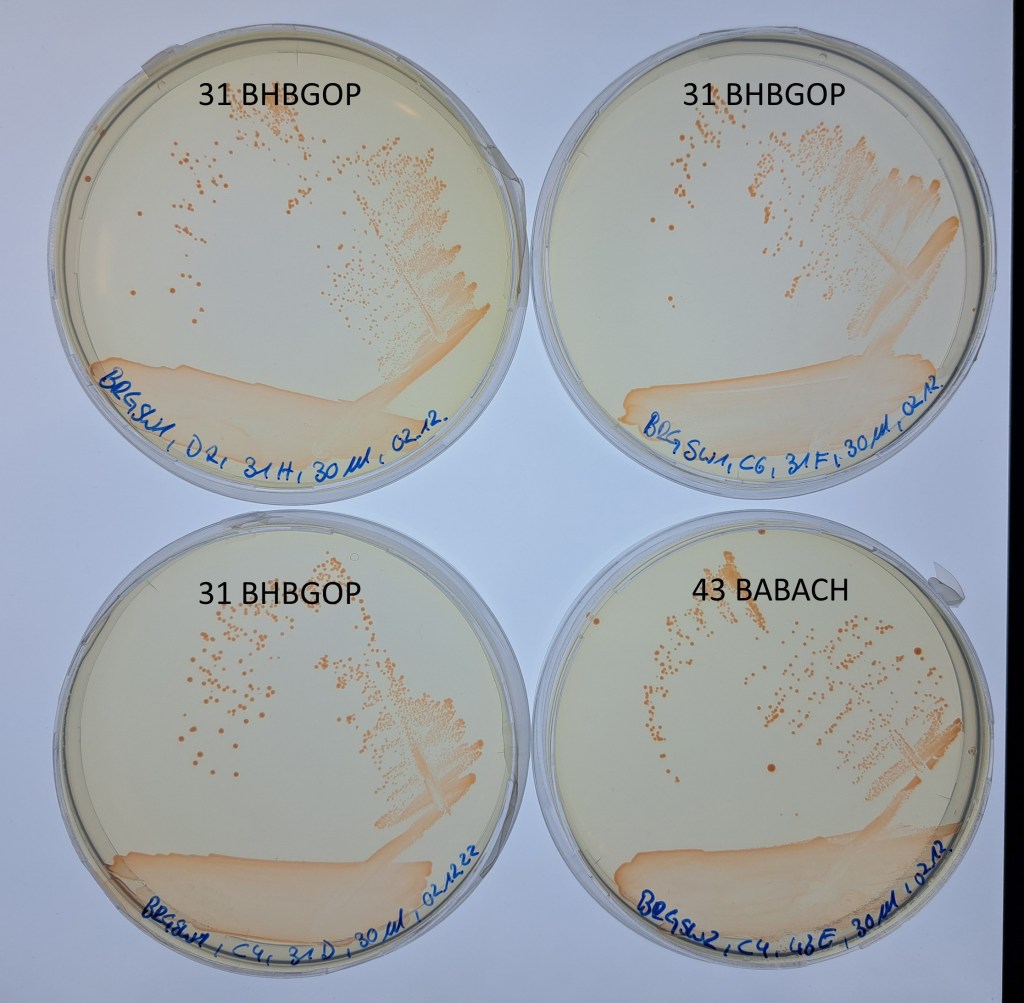
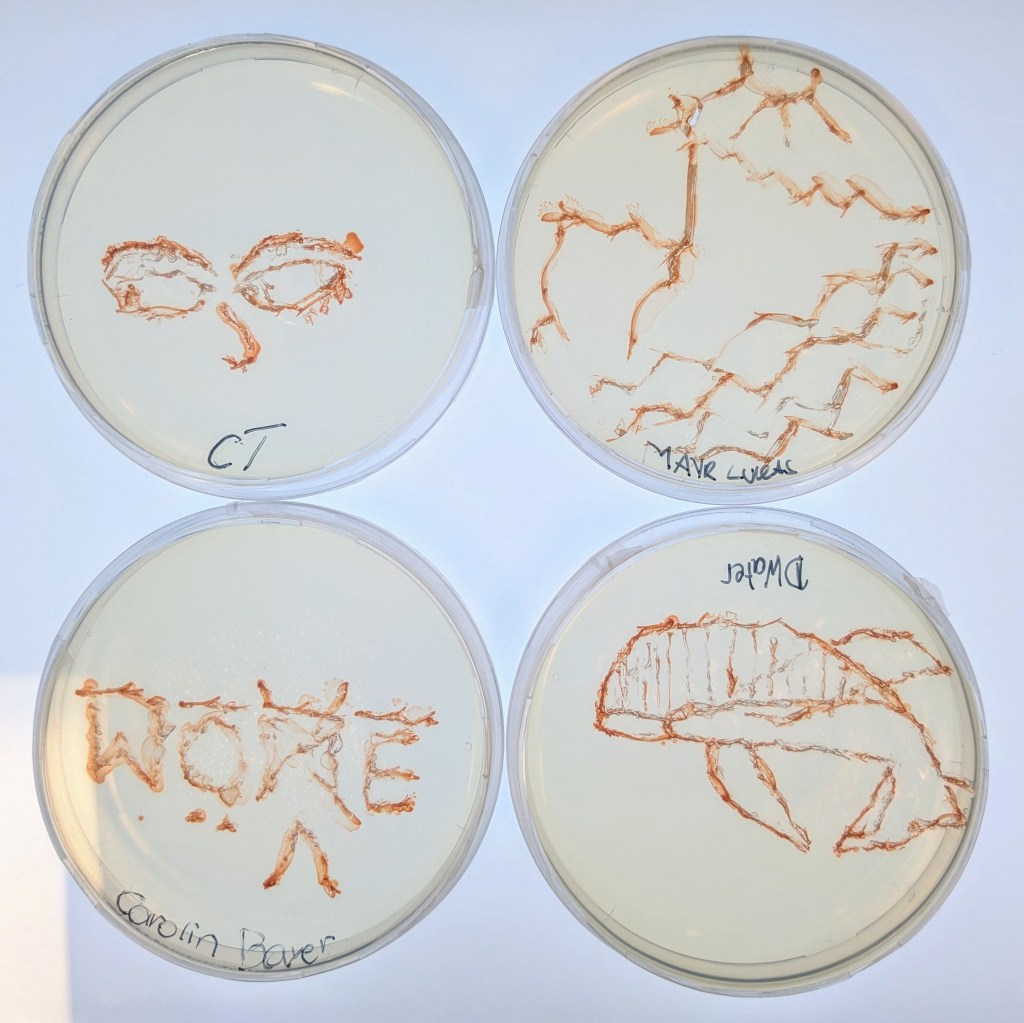

Klasse 5 b (2022/2023) mit Roman Auer


Unsere Bartagamen
1. Workshop
Am 9. November waren wir (Alexandra, Johanna, Ulli und Stefan) zu Besuch am BRG Schloss Wagrain. Da die dortige Klasse 5b recht gross ist, hatte uns Ulli, die auch im letzten Projekt bei den Workshops dabei war, begleitet. zum ganzen Beitrag

2. Workshop

Am 23. November waren wir (Alexandra, Johanna und Stefan) zum zweiten Mal am BRG Schloss Wagrain zu Gast. Diesmal klappte die Anreise reibungslos und wir machten es uns noch für eine Weile vor dem Biosaal gemütlich. zum ganzen Beitrag
3. Die Gewässerproben
Die Schüler/innen hatten Proben von unterschiedlichen Gewässern mitgebracht, sehr beliebt war die Ager und die Vöckla. Für uns sind die Proben sehr interessant, weil wir aus dieser Gegend noch gar keine Proben haben. Das Wasser wurde gefiltert und auf Agarplatten ausgestrichen. Nach zwei Wochen bei uns im Labor war darauf schon einiges gewachsen. Stefan hat eine Platte von jeder Schülerin und jedem Schüler fotografiert:
4. Die ersten Kulturen
Von den Agarplatten haben wir uns die Kolonien rausgesucht, die das typische ‚Aquirufa-Rot‘ zeigen. Von diesen haben wir mit einem (sterilisierten 😉 ) Zahnstocher ganz vorsichtig in ein bisschen flüssiges Medium gegeben. Dort konnten sich die Bakterienzellen weiter vermehren. Wenn die Flüssigkultur wieder das typische Rot aufwies, haben wir davon wieder ein wenig auf eine Agarplatte pipettiert und mit einer Impföse (das sind die langen Stäbe im 1. Bild) verteilt. Dabei streicht man die Kultur so aus, dass man flächiges Wachstum, aber auch einzelne Kolonien bekommt. Einige dieser Platten sehen schon jetzt sehr vielversprechend aus. Ein paar Fotos davon gibt es hier:
5. Auswahl der Kulturen
Im Labor haben sich nun eine ganze Menge Bakterienstämme angesammelt. Sie wachsen jetzt nicht nur auf Agarplatten, sondern auch in Flüssigkulturen. Die Kolben mit flüssigem Medium stehen auf einem Schüttler, wie das Foto zeigt. Hier werden die Bakterien leicht geschaukelt, damit sie genug Sauerstoff bekommen. Nun müssen wir die für unser Projekt interessanten Kulturen auswählen.

Dafür wird von jedem Bakterienstamm ein ganz kleiner Teil der Erbsubstanz analysiert. Dazu muss diese erstmal vervielfältigt werden. Das Verfahren nennt man PCR (Polymerasekettenreaktion). Für die Entwicklung dieser genialen Methode erhielt Karry Mullis 1993 den Nobelpreis für Chemie. Durchgeführt wird sie in einem sogenannten Thermocycler, wie im Bild zu sehen.

Zur Kontrolle werden dann alle erhaltenen Proben auf ein Gel aufgetragen und fotographiert. Die DNA-Proben werden verpackt, zur Post gebracht und nach Deutschland verschickt. Dort werden sie bei der Firma Eurofins sequenziert.

Man erhält nun für jede Probe eine ‚Sequenz‘ das ist nichts anderes als eine Abfolge der Buchstaben A, T, C und G. Für unseren BABACH-43 sieht das dann so aus: ein grüner Peak bedeutet A, ein roter T, ein schwarzer T und ein blauer C. Ein paar hundert Buchstaben bekommen wir so für jeden Stamm.

Die Analyse der Daten ergab: Von 27 von den Schüler/innen gebrachten Wasserproben haben wir aus 6 Bakterienstämme von Aquirufa, das ist die Bakteriengattung, die wir untersuchen wollen, isolieren können. Das ist in über 20 % der Wasserproben und hat uns sehr gefreut.

6. Die Aquirufa Gewässer
Aus diesen von den Schüler/innen selbstausgewählten Gewässern konnten wir aus den im Klassenzimmer bearbeiteten Agarplatten Aquirufa Bakterienstämme isolieren: BHBGOP-31 (Bach bei Gopprechting, Hannah Stockinger), GARBAGER-33 (Gartenteich 🙂 , Julia Schiller), BABACH-43 (Bach bei Bach 😉 Martha Wohlschläger), AGERTUE-44 (Ager Tümpel, Ronja Hauser), WATS-35 (Waldtümpel Schönberg, Kilian Ponget) und DARE-47 (Wasser aus Dachrinne, Sonia Qaiser).
Von fünf dieser Bakterienstämme werden wir das ganze Genom sequenzieren lassen, das bedeutet nicht wie bei der Vorauswahl ein paar hundert Buchstaben, sondern ca. 3 Millionen Buchstaben. Wir können schon mal verraten, aus welche Gewässern die Stämme sind: DARE, WATS, BHBGOP, BABACH und GARBAGER. Wir haben auch schon einen Verdacht, bei welchen es sich um eine neue Art handelt, aber um das sicher sagen zu können, brauchen wir die Aufschlüsselung des gesamten Genoms.

7. Dritter Besuch

Am 22.06 konnten die SchülerInnen ihre Informatikkünste in der dritten Runde der Workshops beweisen. zum ganzen Beitrag
8. Sommerpraktikum in Mondsee und Probenahme
Im August war unsere letzte Praktikantengruppe bei uns im Institut in Mondsee. Martin und Joachim haben fleissig im Labor gearbeitet. Mit Stefan ging es dann zur Probenahme zum ganzen Beitrag

9. Agar Art
Während seines Sommerpraktikums hat Joachim Göbl vom BRG Schloss Wagrain mit unseren Aquirufa Kulturen auf Agarplatten gemalt. Hier sind ein paar seiner Kunstwerke. In der oberen Reihe der Mondsee mit dem Schafberg und der Drachenwand im Hintergrund.




10. Erste Publikation erschienen
Unsere erste wissenschaftliche Publikation im Projekt ist erschienen und hier verfügbar.
Sie enthält die Beschreibung einer neuen Bakterienart aus dem Leopoldskroner Weiher. Sie ist eine wirkliche Gemeinschaftsarbeit. Unsere Kooperationspartner von der DSMZ Braunschweig und den GUE Austria sowie Schülerinnen und Schüler vom BORG Nonntal, dem BG Vöcklabruck und dem BRG Schloss Wagrain haben mitgewirkt. Alle sind in der Danksagung namentlich erwähnt. Ganz ❤️ lichen Dank 😊.

11. Probenahme an Ager und Vöckla
Zur Frühjahrsprobenahme waren wir mit der 6b vom BRG Schloß Wagrain am Zusammenfluss von Vöckla und Ager. Im zweiten Teil des Projektes wollen wir direkt aus Wasserproben mit einem molekularen Marker die Artenvielfalt und Verbreitung unserer Aquirufa Bakterien erforschen. Dafür waren die Bakterien Kulturen, die wir mit Hilfe der Schüler/innen gewonnen hatten, eine wichtige Vorarbeit. Mit Hilfe unseres ‚hochwissenschaftlichen‘ Probenehmers wurde Wasser entnommen und verschiedene Parameter gemessen. Eine Schülergruppe engagierte sich sehr eine Strecke für die Bestimmung der Fließgeschwindigkeit auszumessen. Mit Hilfe eines Tracers und der guten Physik- und Mathe Kenntnisse von einigen Schülerinnen könnten wir diese dann auch berechnen. Ganz ❤️lichen Dank an die Klasse und ihren Lehrer Roman Auer. Wir freuen uns auf euren Besuch im nächsten Schuljahr 😊.





12. Wissenschaftliche Publikation erschienen
Unsere 3. wissenschaftliche Publikation ist erschienen und hier online verfügbar. Ca. 130 Citizen Scientist haben dabei mitgewirkt. Sechs Schulklassen und weitere Citizen Scientists haben Wasserproben aus selbst gewählten Gewässern genommen…hier gehts zum Beitrag

13. Besuch in Mondsee
Gleich nach Ostern 2025 war die Klasse zu uns am Forschungsinstitut in Mondsee zu Besuch. Inzwischen sind über zwei Jahre seit dem ersten Workshop vergangen. Durch die Mitarbeit der Klasse sind wir mit unserer Forschung ein ganzes Stück weitergekommen. Aus den im zweiten Workshop angelegten Bakterienkulturen konnten wir einige Bakterienstämme unserer Aquirufa Bakterien gewinnen. Die Daten dazu sind in eine wissenschaftliche Publikation eingeflossen (siehe oben). Nun wollen wir eine Methode entwickeln, mit der wir die einzelnen bekannten und auch noch unentdeckten Aquirufa Arten direkt aus einer Wasserprobe anhand der darin enthaltenen DNA nachweisen wollen. Bis jetzt klappt das noch nicht sehr gut, aber wir sind zuversichtlich. Dann werden auch die mit der Klasse genommenen Wasserproben aus Ager und Vöckla ausgewertet. Wir sind schon gespannt! An verschiedenen Stationen wurde das Institut erkundet. Mit einer Aquirufa Kultur wurde auf Agarplatten gemalt, die Kunstwerke sind unten in der Galerie zu sehen. Zum Schluß gab es noch eine gemeinsame Jause und zur Erinnerung wurde ein Gruppenfoto gemacht. Wir wünschen der Klasse und ihren Lehrer/innen alles Gute und halten sie über den Fortgang des Projektes auf dem Laufenden.
14. Erste Ergebnisse Wasserprobe aus der Vöckla

Vor fast genau einem Jahr haben wir mit der heutigen 7b mit ihrem Lehrer Roman Auer am Zusammenfluss der Vöckla und Ager Wasserproben genommen. Wir sind dabei eine Methode zu entwickeln, um die Biodiversität unserer Süßwasserbakterien Gattung Aquirufa direkt anhand der DNA in der Wasserproben zu erforschen. Unsere Masterstudentin Raphaela Meixner hat nun erste Ergebnisse. Erstaunlicherweise ist die Aquirufa Biodiversität in der Vöckla sehr hoch. Insgesamt 22 Arten, die wahrscheinlich zu Aquirufa gehören, konnte Raphaela nachweisen😊. Noch erstaunlicher ist, dass wir davon nur fünf Arten kennen, der Rest gehört wohl zu unbekannten Arten. Wir freuen uns über das Ergebnis sehr. Es zeigt, wie wertvoll die Beiträge der Schüler/innen für unsere Arbeit sind. Erst durch die früheren Wasserproben der Schüler/innen aus den Workshops vom ersten Teil des Projektes sind wir auf die Vöckla aufmerksam geworden. Wir haben außerdem gelernt, dass es noch sehr viel zu tun gibt. 17 Arten alleine in der Vöckla warten noch auf ihre wissenschaftliche Beschreibung.
15. Sommerpraktikum von Eva

Im Sommer 2025 waren zwei Schülerinnen bei uns im Labor für ein Praktikum zu Gast. Anna hat gerade am BORG Nonntal ihre Matura mit Auszeichnung bestanden und Eva wird ihren Abschluß nächstes Jahr am BRG Schloss Wagrain machen. Die Beiden waren sehr fleißig im Gelände und Labor, hier ist ihr Bericht: